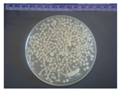
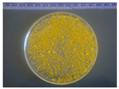
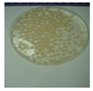
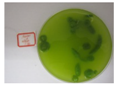
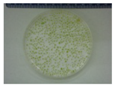
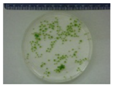
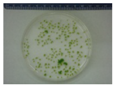

Review of Microalgae Harvesting via Co-Pelletization with Filamentous Fungus
Abstract
:1. Introduction
2. Harvesting Methods of Microalgae
2.1. Flotation
2.2. Centrifugation
2.3. Sedimentation
- v particle settling velocity (m/s);
- r cell radius (m);
- g gravitational acceleration (9.81) (m/s2);
- ρp mass density particle (kg/m3);
- ρf mass density fluid (kg/m3);
- η dynamic viscosity (N s/m2).
2.4. Flocculation
2.5. Filtration
3. Fugal Pelletization
3.1. Microscopic Morphology
3.2. Macroscopic Morphology and Pelletization of Filamentous Fungi
3.3. Application of Pelletized Growth on Microbial Oil Accumulation


4. Pelletization of Filamentous Fungi on Harvesting Microalgae Cells
| Fungal species | M. isabellina | M. circinelloides | RLG 9902 | Ted S-OSU | ATCC 9642 |
|---|---|---|---|---|---|
| Fungal pellets | ![]() | ![]() | ![]() | ![]() | ![]() |
| Co-pellets | No pellets | ![]() | ![]() | ![]() | ![]() |
4.1. Mechanism of Fungal Algae Co-Pelletization
4.2. Impact on Subsequent Downstreaming Processing of Microalgae Cells
4.3. Economic Feasibility and Scale-Up
5. Conclusions
Conflicts of Interest
References
- Borowitzka, M.A. Commercial production of microalgae: Ponds, tanks, tubes and fermenters. J. Biotechnol. 1999, 70, 313–321. [Google Scholar] [CrossRef]
- Miao, X.; Wu, Q. Biodiesel production from heterotrophic microalgal oil. Bioresour. Technol. 2006, 97, 841–846. [Google Scholar] [CrossRef]
- Chisti, Y. Biodiesel from microalgae. Biotechnol. Adv. 2007, 25, 294–306. [Google Scholar] [CrossRef] [PubMed]
- Tsukahara, K.; Sawayama, S. Liquid fuel production using microalgae. J. Jpn. Pet. Inst. 2005, 48, 251–259. [Google Scholar] [CrossRef]
- Xia, C.; Zhang, J.; Zhang, W.; Hu, B. A new cultivation method for microbial oil production: Cell pelletization and lipid accumulation by Mucor circinelloides. Biotechnol. Biofuels 2011, 4. [Google Scholar] [CrossRef]
- Fakas, S.; Papanikolaou, S.; Batsos, A.; Galiotou-Panayotou, M.; Mallouchos, A.; Aggelis, G. Evaluating renewable carbon sources as substrates for single cell oil production by Cunninghamella echinulata and Mortierella isabellina. Biomass Bioenergy 2009, 33, 573–580. [Google Scholar] [CrossRef]
- Heredia-Arroyo, T.; Wei, W.; Ruan, R.; Hu, B. Mixotrophic cultivation of Chlorella vulgaris and its potential application for the oil accumulation from non-sugar materials. Biomass Bioenergy 2011, 35, 2245–2253. [Google Scholar] [CrossRef]
- Yang, C.; Hua, Q.; Shimizu, K. Energetics and carbon metabolism during growth of microalgal cells under photoautotrophic, mixotrophic and cyclic light-autotrophic/dark-heterotrophic conditions. Biochem. Eng. J. 2000, 6, 87–102. [Google Scholar] [CrossRef] [PubMed]
- Wang, B.; Li, Y.; Wu, N.; Lan, C.Q. CO2 bio-mitigation using microalgae. Appl. Microbiol. Biotechnol. 2008, 79, 707–718. [Google Scholar] [CrossRef] [PubMed]
- Benemann, J.R. CO2 mitigation with microalgae systems. Energy Convers. Manag. 1997, 38, S475–S479. [Google Scholar] [CrossRef]
- Zeiler, K.G.; Heacox, D.A.; Toon, S.T.; Kadam, K.L.; Brown, L.M. The use of microalgae for assimilation and utilization of carbon-dioxide from fossil fuel-fired power-plant flue-gas. Energy Convers. Manag. 1995, 36, 707–712. [Google Scholar] [CrossRef]
- Mosojídek, J.; Torzillo, G.; Sven Erik, J.; Brian, F. Mass Cultivation of Freshwater Microalgae. In Encyclopedia of Ecology; Academic Press: Oxford, UK, 2008; pp. 2226–2235. [Google Scholar]
- Liang, Y.N.; Sarkany, N.; Cui, Y. Biomass and lipid productivities of Chlorella vulgaris under autotrophic, heterotrophic and mixotrophic growth conditions. Biotechnol. Lett. 2009, 31, 1043–1049. [Google Scholar] [CrossRef] [PubMed]
- Brennan, L.; Owende, P. Biofuels from microalgae—A review of technologies for production, processing, and extractions of biofuels and co-products. Renew. Sustain. Energy Rev. 2010, 14, 557–577. [Google Scholar] [CrossRef]
- Wu, Q.; Xiong, W. Method for Producing Biodiesel from an Alga. U.S. Patent 2009/0298159A1, 3 December 2009. [Google Scholar]
- Olaizola, M. Commercial development of microalgal biotechnology: From the test tube to the marketplace. Biomol. Eng. 2003, 20, 459–466. [Google Scholar] [CrossRef] [PubMed]
- Park, J.B.K.; Craggs, R.J.; Shilton, A.N. Wastewater treatment high rate algal ponds for biofuel production. Bioresour. Technol. 2011, 102, 35–42. [Google Scholar] [CrossRef] [PubMed]
- Shelef, G.; Sukenik, A.; Green, M. Microalgae Harvesting and Processing: A Literature Review; Technion Research and Development Foundation Ltd.: Haifa, Israel, 1984. [Google Scholar]
- Edzwald, J.K. Algae, bubbles, coagulants, and dissolved air flotation. Water Sci. Technol. 1993, 27, 67–81. [Google Scholar]
- Christenson, L.; Sims, R. Production and harvesting of microalgae for wastewater treatment, biofuels, and bioproducts. Biotechnol. Adv. 2011, 29, 686–702. [Google Scholar] [CrossRef] [PubMed]
- Sim, T.S.; Goh, A.; Becker, E.W. Comparison of centrifugation, dissolved air flotation and drum filtration techniques for harvesting sewage-grown algae. Biomass 1988, 16, 51–62. [Google Scholar] [CrossRef]
- Heasman, M.; Diemar, J.; O’Connor, W.; Sushames, T.; Foulkes, L. Development of extended shelf-life microalgae concentrate diets harvested by centrifugation for bivalve molluscs—A summary. Aquac. Res. 2000, 31, 637–659. [Google Scholar] [CrossRef]
- Molina Grima, E.; Belarbi, E.-H.; Acién Fernández, F.G.; Robles Medina, A.; Chisti, Y. Recovery of microalgal biomass and metabolites: Process options and economics. Biotechnol. Adv. 2003, 20, 491–515. [Google Scholar] [CrossRef] [PubMed]
- Bosma, R.; van Spronsen, W.A.; Tramper, J.; Wijffels, R.H. Ultrasound, a new separation technique to harvest microalgae. J. Appl. Phycol. 2003, 15, 143–153. [Google Scholar] [CrossRef]
- Shen, Y.; Yuan, W.; Pei, Z.J.; Wu, Q.; Mao, E. Microalgae mass production methods. Trans. ASABE 2009, 52, 1275–1287. [Google Scholar] [CrossRef]
- Schenk, P.M.; Thomas-Hall, S.R.; Stephens, E.; Marx, U.C.; Mussgnug, J.H.; Posten, C.; Kruse, O.; Hankamer, B. Second generation biofuels: High-efficiency microalgae for biodiesel production. Bioenergy Res. 2008, 1, 20–43. [Google Scholar] [CrossRef]
- Munoz, R.; Guieysse, B. Algal-bacterial processes for the treatment of hazardous contaminants: A review. Water Res. 2006, 40, 2799–2815. [Google Scholar] [CrossRef] [PubMed]
- Ives, K.J. The significance of surface electric charge on algae in water purification. J. Biochem. Microbiol. Technol. Eng. 1959, 1, 37–47. [Google Scholar] [CrossRef]
- Golueke, C.G.; Oswald, W.J. Harvesting and processing sewage-grown planktonic algae. J. Water Pollut. Control Fed. 1965, 37, 471–498. [Google Scholar]
- Koopman, B.; Lincoln, E.P. Autoflotation harvesting of algae from high-rate pond effluents. Agric. Wastes 1983, 5, 231–246. [Google Scholar] [CrossRef]
- Wu, Z.; Zhu, Y.; Huang, W.; Zhang, C.; Li, T.; Zhang, Y.; Li, A. Evaluation of flocculation induced by pH increase for harvesting microalgae and reuse of flocculated medium. Bioresour. Technol. 2012, 110, 496–502. [Google Scholar] [CrossRef] [PubMed]
- Poelman, E.; De Pauw, N.; Jeurissen, B. Potential of electrolytic flocculation for recovery of micro-algae. Resour. Conserv. Recycl. 1997, 19, 1–10. [Google Scholar] [CrossRef]
- Li, Y.; Horsman, M.; Wu, N.; Lan, C.Q.; Dubois-Calero, N. Biofuels from microalgae. Biotechnol. Prog. 2008, 24, 815–20. [Google Scholar] [PubMed]
- Sharma, B.R.; Dhuldhoya, N.C.; Merchant, U.C. Flocculants—An ecofriendly approach. J. Polym. Environ. 2006, 14, 195–202. [Google Scholar] [CrossRef]
- Milledge, J.J.; Heaven, S. A review of the harvesting of micro-algae for biofuel production. Rev. Environ. Sci. Biotechnol. 2013, 12, 165–178. [Google Scholar] [CrossRef]
- Jaouen, P.; Vandanjon, L.; Quéméneur, F. The shear stress of microalgal cell suspensions (Tetraselmis suecica) in tangential flow filtration systems: The role of pumps. Bioresour. Technol. 1999, 68, 149–154. [Google Scholar] [CrossRef]
- Rossignol, N.; Vandanjon, L.; Jaouen, P.; Quéméneur, F. Membrane technology for the continuous separation microalgae/culture medium: Compared performances of cross-flow microfiltration and ultra-filtration. Aquac. Eng. 1999, 20, 191–208. [Google Scholar] [CrossRef]
- Morris, I.; Yentsch, C.S. A new method for concentrating phytoplankton by filtration with continuous stirring. Limnol. Oceanogr. 1972, 17, 490–493. [Google Scholar] [CrossRef]
- Wilkie, A.C.; Mulbry, W.W. Recovery of dairy manure nutrients by benthic freshwater algae. Bioresour. Technol. 2002, 84, 81–91. [Google Scholar] [CrossRef] [PubMed]
- Johnson, M.B.; Wen, Z.Y. Development of an attached microalgal growth system for biofuel production. Appl. Microbiol. Biotechnol. 2010, 85, 525–534. [Google Scholar] [CrossRef] [PubMed]
- Uduman, N.; Qi, Y.; Danquah, M.K.; Forde, G.M.; Hoadley, A. Dewatering of microalgal cultures: A major bottleneck to algae-based fuels. J. Renew. Sustain. Energy 2010, 2. [Google Scholar] [CrossRef]
- Rajab, A.H. Micro-Algae Removal in Domestic Wastewater Using Aspergillus Flavus Soft Pellets as a Bio-Coagulant. Ph.D. Thesis, Universiti Putra Malaysia, Selangor, Malaysia, 2007. [Google Scholar]
- Gibbs, P.A.; Seviour, R.J.; Schmid, F. Growth of filamentous fungi in submerged culture: Problems and possible solutions. Crit. Rev. Biotechnol. 2000, 20, 17–48. [Google Scholar] [CrossRef] [PubMed]
- Cox, P.W.; Paul, G.C.; Thomas, C.R. Image analysis of the morphology of filamentous micro-organisms. Microbiology 1998, 144, 817–827. [Google Scholar] [CrossRef] [PubMed]
- Znidarsic, P.; Pavko, A. The morphology of filamentous fungi in submerged cultivations as a bioprocess parameter. Food Technol. Biotechnol. 2001, 39, 237–252. [Google Scholar]
- Zmak, P.M.; Podgornik, A.; Podgornik, H.; Koloini, T. Impact of pellet size on growth and lignin peroxidase activity of Phanerochaete chrysosporium. World J. Microbiol. Biotechnol. 2006, 22, 1243–1249. [Google Scholar] [CrossRef]
- Krull, R.; Cordes, C.; Horn, H.; Kampen, I.; Kwade, A.; Neu, T.R.; Nortemann, B. Morphology of Filamentous Fungi: Linking Cellular Biology to Process Engineering Using Aspergillus niger. In Biosystems Engineering II: Linking Cellular Networks and Bioprocesses; Wittmann, C., Krull, R., Eds.; Springer: Heidelberg, Germany, 2010; Volume 121, pp. 1–21. [Google Scholar]
- Krull, R.; Wucherpfennig, T.; Esfandabadi, M.E.; Walisko, R.; Melzer, G.; Hempel, D.C.; Kampen, I.; Kwade, A.; Wittmann, C. Characterization and control of fungal morphology for improved production performance in biotechnology. J Biotechnol. 2013, 163, 112–123. [Google Scholar] [CrossRef] [PubMed]
- Osherov, N.; May, G.S. The molecular mechanisms of conidial germination. FEMS Microbiol. Lett. 2001, 199, 153–160. [Google Scholar] [CrossRef] [PubMed]
- Metz, B.; Kossen, N.W.F. The growth of molds in the form of pellets—A literature review. Biotechnol. Bioeng. 1977, 19, 781–799. [Google Scholar] [CrossRef]
- Trinci, A.P. A study of the kinetics of hyphal extension and branch initiation of fungal mycelia. J. Gen. Microbiol. 1974, 81, 225–236. [Google Scholar] [CrossRef] [PubMed]
- Grimm, L.H.; Kelly, S.; Hengstler, J.; Gobel, A.; Krull, R.; Hempel, D.C. Kinetic studies on the aggregation of Aspergillus niger conidia. Biotechnol. Bioeng. 2004, 87, 213–218. [Google Scholar] [CrossRef] [PubMed]
- Bergter, F. Kinetic-model of mycelial growth. Z. Allg. Mikrobiol. 1978, 18, 143–145. [Google Scholar] [CrossRef] [PubMed]
- Prosser, J.I.; Trinci, A.P. A model for hyphal growth and branching. J. Gen. Microbiol. 1979, 111, 153–164. [Google Scholar] [CrossRef] [PubMed]
- Papagianni, M.; Stanhope, R. Should serum IGF-I concentrations be monitored routinely during growth hormone therapy? J. Pediatr. Endocrinol. Metab. 2004, 17, 141–142. [Google Scholar] [CrossRef] [PubMed]
- Hu, B.; Chen, S.L. Biological hydrogen production using chloroform-treated methanogenic granules. Appl. Biochem. Biotechnol. 2008, 148, 83–95. [Google Scholar] [CrossRef] [PubMed]
- Hu, B.; Chen, S.L. Pretreatment of methanogenic granules for immobilized hydrogen fermentation. Int. J. Hydrog. Energy 2007, 32, 3266–3273. [Google Scholar] [CrossRef]
- Hu, B.; Zhou, X.; Forney, L.; Chen, S.L. Changes in microbial community composition following treatment of methanogenic granules with chloroform. Environ. Prog. Sustain. Energy 2009, 28, 60–71. [Google Scholar] [CrossRef]
- Liao, W.; Liu, Y.; Chen, S.L. Studying pellet formation of a filamentous fungus Rhizopus oryzae to enhance organic acid production. Appl. Biochem. Biotechnol. 2007, 137, 689–701. [Google Scholar] [PubMed]
- Vecht-Lifshitz, S.E.; Magdassi, S.; Braun, S. Pellet formation and cellular aggregation in Streptomyces tendae. Biotechnol. Bioeng. 1990, 35, 890–896. [Google Scholar] [CrossRef] [PubMed]
- Braun, S.; Vechtlifshitz, S.E. Mycelial morphology and metabolite production. Trends Biotechnol. 1991, 9, 63–68. [Google Scholar] [CrossRef]
- Liu, Y.; Liao, W.; Chen, S. Co-production of lactic acid and chitin using a pelletized filamentous fungus Rhizopus oryzae cultured on cull potatoes and glucose. J. Appl. Microbiol. 2008, 105, 1521–1528. [Google Scholar] [CrossRef] [PubMed]
- Xia, C.; Zhang, J.; Hu, B. Microbial Oil Accumulation via Pelletized Cultivation of Mucor Circinelloides. In Proceedings of the 33rd Symposium on Biotechnology for Fuels and Chemicals, Seattle, WA, USA, 2–5 May 2011.
- Zhang, J.G.; Hu, B. A Novel Method to Harvest Microalgae via Fungal Pelletization. In Proceedings of the AIChE Annual Meeting, Minneapolis, MN, USA, 16–21 October 2011.
- Zhou, W.G.; Cheng, Y.L.; Li, Y.; Wan, Y.Q.; Liu, Y.H.; Lin, X.Y.; Ruan, R. Novel fungal pelletization-assisted technology for algae harvesting and wastewater treatment. Appl. Biochem. Biotechnol. 2012, 167, 214–228. [Google Scholar] [CrossRef] [PubMed]
- Zhang, J.G.; Hu, B. A novel method to harvest microalgae via co-culture of filamentous fungi to form cell pellets. Bioresour. Technol. 2012, 114, 529–535. [Google Scholar] [CrossRef] [PubMed]
- Zhou, W.G.; Min, M.; Hu, B.; Ma, X.C.; Liu, Y.H.; Wang, Q.; Shi, J.; Chen, P.; Ruan, R. Filamentous fungi assisted bio-flocculation: A novel alternative technique for harvesting heterotrophic and autotrophic microalgal cells. Sep. Purif. Technol. 2013, 107, 158–165. [Google Scholar] [CrossRef]
- Mackay, S.; Pereira Gomes, E.; Rossi, P.; Schwitzguebel, J.-P.; Holliger, C. Pelletization of Micro-Algae by Induced Lichen Formation through Co-Culture with Filamentous Fungi. In Proceedings of the SME 2013 5th Swiss Microbial Ecology Meeting, Murten, Switzerland, 4–6 February 2013.
- Zoller, S.; Lutzoni, F. Slow algae, fast fungi: Exceptionally high nucleotide substitution rate differences between lichenized fungi Omphalina and their symbiotic green algae Coccomyxa. Mol. Phylogenet. Evol. 2003, 29, 629–640. [Google Scholar] [CrossRef] [PubMed]
- Honegger, R. Functional-aspects of the lichen symbiosis. Annu. Rev. Plant Physiol. Plant Mol. Biol. 1991, 42, 553–578. [Google Scholar] [CrossRef]
- Biliouris, K.; Babson, D.; Schmidt-Dannert, C.; Kaznessis, Y.N. Stochastic simulations of a synthetic bacteria-yeast ecosystem. BMC Syst. Biol. 2012, 6. [Google Scholar] [CrossRef] [PubMed]
- Mee, M.T.; Wang, H.H. Engineering ecosystems and synthetic ecologies. Mol. Biosyst. 2012, 8, 2470–2483. [Google Scholar] [CrossRef] [PubMed]
- Hadjoudja, S.; Deluchat, V.; Baudu, M. Cell surface characterisation of Microcystis aeruginosa and Chlorella vulgaris. J. Colloid Interface Sci. 2010, 342, 293–299. [Google Scholar] [CrossRef] [PubMed]
- Henderson, R.K.; Parsons, S.A.; Jefferson, B. Successful removal of algae through the control of zeta potential. Sep. Sci. Technol. 2008, 43, 1653–1666. [Google Scholar] [CrossRef]
- Holder, D.J.; Kirkland, B.H.; Lewis, M.W.; Keyhani, N.O. Surface characteristics of the entomopathogenic fungus Beauveria (Cordyceps) bassiana. Microbiology 2007, 153, 3448–3457. [Google Scholar] [CrossRef] [PubMed]
- Olguin, E.J. Dual purpose microalgae-bacteria-based systems that treat wastewater and produce biodiesel and chemical products within a biorefinery. Biotechnol. Adv. 2012, 30, 1031–1046. [Google Scholar] [CrossRef] [PubMed]
- Van den Hende, S.; Vervaeren, H.; Desmet, S.; Boon, N. Bioflocculation of microalgae and bacteria combined with flue gas to improve sewage treatment. New Biotechnol. 2011, 29, 23–31. [Google Scholar] [CrossRef]
- Xie, G.J.; Liu, B.F.; Xing, D.F.; Nan, J.; Ding, J.; Ren, N.Q. Photo-fermentative bacteria aggregation triggered by L-cysteine during hydrogen production. Biotechnol. Biofuels 2013, 6. [Google Scholar] [CrossRef] [PubMed]
- Lee, J.; Cho, D.H.; Ramanan, R.; Kim, B.H.; Oh, H.M.; Kim, H.S. Microalgae-associated bacteria play a key role in the flocculation of Chlorella vulgaris. Bioresour. Technol. 2013, 131, 195–201. [Google Scholar] [CrossRef] [PubMed]
- Acharya, P.B.; Acharya, D.K.; Modi, H.A. Optimization for cellulase production by Aspergillus niger using saw dust as substrate. Afr. J. Biotechnol. 2008, 7, 4147–4152. [Google Scholar]
- Harun, R.; Danquah, M.K. Enzymatic hydrolysis of microalgal biomass for bioethanol production. Chem. Eng. J. 2011, 168, 1079–1084. [Google Scholar] [CrossRef]
- Wittenberg, K.M. Preservation of high-moisture hay in storage through the use of forage additives. Can. J. Anim. Sci. 1991, 71, 429–437. [Google Scholar] [CrossRef]
- Yin, L.J.; Jiang, S.T.; Pon, S.H.; Lin, H.H. Hydrolysis of Chlorella by Cellulomonas sp. YJ5 cellulases and its biofunctional properties. J. Food Sci. 2010, 75, H317–H323. [Google Scholar] [CrossRef] [PubMed]
- Fu, C.-C.; Hung, T.-C.; Chen, J.-Y.; Su, C.-H.; Wu, W.-T. Hydrolysis of microalgae cell walls for production of reducing sugar and lipid extraction. Bioresour. Technol. 2010, 101, 8750–8754. [Google Scholar] [CrossRef] [PubMed]
- Mehl, H.L.; Jaime, R.; Callicott, K.A.; Probst, C.; Garber, N.P.; Ortega-Beltran, A.; Grubisha, L.C.; Cotty, P.J. Aspergillus flavus diversity on crops and in the environment can be exploited to reduce aflatoxin exposure and improve health. Annu. N. Y. Acad. Sci. 2012, 1273, 7–17. [Google Scholar] [CrossRef]
© 2013 by the authors licensee MDPI, Basel, Switzerland. This article is an open access article distributed under the terms and conditions of the Creative Commons Attribution license ( http://creativecommons.org/licenses/by/3.0/).
Share and Cite
Gultom, S.O.; Hu, B. Review of Microalgae Harvesting via Co-Pelletization with Filamentous Fungus. Energies 2013, 6, 5921-5939. https://doi.org/10.3390/en6115921
Gultom SO, Hu B. Review of Microalgae Harvesting via Co-Pelletization with Filamentous Fungus. Energies. 2013; 6(11):5921-5939. https://doi.org/10.3390/en6115921
Chicago/Turabian StyleGultom, Sarman Oktovianus, and Bo Hu. 2013. "Review of Microalgae Harvesting via Co-Pelletization with Filamentous Fungus" Energies 6, no. 11: 5921-5939. https://doi.org/10.3390/en6115921
APA StyleGultom, S. O., & Hu, B. (2013). Review of Microalgae Harvesting via Co-Pelletization with Filamentous Fungus. Energies, 6(11), 5921-5939. https://doi.org/10.3390/en6115921